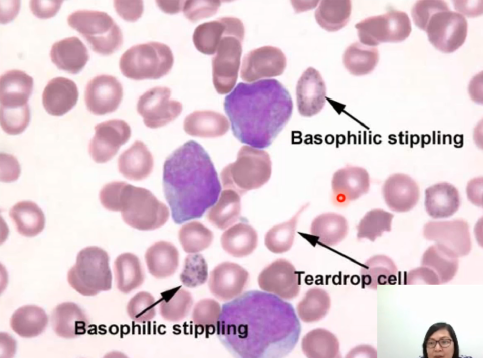
<p>- Basophilic Stippling, ALA and</p><p>Porphyrin in the urine</p>

1/125
Looks like no tags are added yet.
Name | Mastery | Learn | Test | Matching | Spaced | Call with Kai |
|---|
No analytics yet
Send a link to your students to track their progress
TOXICOLOGY
Study of toxic drugs or poisons
- Effects and properties of poison
- Isolation and identification of poison
- Action of poisons to living tissue
- Determination of lethal dose
- Determination of antidotes (ang tambal)
● CBC
● Urinalysis - most of this toxicity will affect the kidney
● Blood-Urine Nitrogen (in relation to the kidney)
● Electrolyte analysis
● Blood gas together with the toxic substance that is measured
In cases of drug overdose, aside from the testing for the presence of
that specific drug in the system, e-apil pud ug test si:
Toxicology
- The study of the adverse effect of xenobiotics to
the human body
Xenobiotics
substances that are foreign to the body such as
poisons, toxins, toxic drugs (antibiotics)
50%
EXPOSURE TO TOXINS
- intentional/suicide (ginusto)
30%
EXPOSURE TO TOXINS
accidental
20%
EXPOSURE TO TOXINS
- homicide/occupational (from work)
Ingestion
ROUTE OF EXPOSURE
- swallowing of substance through the mouth and
into the stomach.
- Generally followed by its entrance into the small
intestine
Inhalation
ROUTE OF EXPOSURE
- breathing causes us to inhale substances which in
return travel enroute to the lungs.
- Our lungs are so rich in blood vessels that any
substance inhaled into the lungs are readily
absorbed into the bloodstream
Transdermal
absorption
ROUTE OF EXPOSURE
- entering the body through the skin.
- Substances that absorb through the skin
sometimes further assimilate into the blood
system
Ingestion/Inhalation
ROUTE OF EXPOSURE
Aside from that, the most common route of exposure
pass the cellular barrier
ROUTE OF EXPOSURE
○ If maingest siya goes to the GI tract and passively diffuse into the
circulation kay maabsorb siya sa intestine. Because these toxins are
able to _____________.
produce
systemic effects
ROUTE OF EXPOSURE
In the circulation, it will then ___________. It can go to any organ (it could affect your heart,
liver, kidney).
produce local effect such as diarrhea,
bleeding, malabsorption of nutrients if dili muagi sa GIT.
ROUTE OF EXPOSURE
○ If inhaled or transdermal absorption, it will not produce systemic
effect instead it will only ________________
Mechanistic
BRANCHES OF TOXICOLOGY
- cellular, molecular, and biochemical effect of
xenobiotics within the context of dose response
relationship (the higher dose = the more toxic)
that will assess potential toxicity of new
chemicals
Descriptive
BRANCHES OF TOXICOLOGY
it will describe or compare risk assessment of
toxicity test
Regulatory
BRANCHES OF TOXICOLOGY
- it will formulate regulatory policies to protect
humans (more on government side)
Forensic
BRANCHES OF TOXICOLOGY
- deals with kanang mga namatay, tanawon kung
suicide ba or homicide. Pwede iexamine ang
corpses.
Clinical
BRANCHES OF TOXICOLOGY
It will study the relationship between the
xenobiotic and the disease
Environmental
BRANCHES OF TOXICOLOGY
- deals with the sources of the toxin, transport,
transformation of the toxin and how human will
be able to come in contact with these toxins
Acute Toxicity
TERMINOLOGIES
- there is a single short-term exposure to a
substance.
- Once or short-term lang siya na expose sa
substance
Chronic
Toxicity
TERMINOLOGIES
- repeated exposure for an extended period of
time
𝑇𝐷50
- TD=Toxic Dose
TERMINOLOGIES
- This is the dose that will predict when mag
produce ug toxic response in half of the
population, meaning 50% of the population
𝐿𝐷50
- LD= Lethal Dose
TERMINOLOGIES
- this is the dose that will predict the dose that will
have a lethal effect on the 50% of the population
● Lethal means death
𝐸𝐷50
- ED = Effective Dose
TERMINOLOGIES
- This is the dose that will predict an effective or
therapeutic dose to the 50% of the population
METHODS OF DETERMINATION
- Immunoassay (katong mga EMIT mao to sila ang mga common)
- Chromatographic Techniques
TLC
- Thin-layer Chromatography
METHODS OF DETERMINATION
- limited sensitivity, results must be confirmed with
another method
HPLC
METHODS OF DETERMINATION
- High Performance Liquid Chromatography
GC-MS
Gas Chromatography-Mass Spectrometry
METHODS OF DETERMINATION
-
- highly sensitive, reference method
- Alcohol
- Carbon Monoxide
- Cyanide
- Metals
- Drugs of Abuse
TOXIC AGENTS
ALCOHOL
Major substance abuse problem
Ethanol
ALCOHOL
Principle
pharmacologic
function
- CNS depressant
- Increases heart rate and blood
pressure

Ethanol Effects
ALCOHOL
- Skill thought/attention
diminishes
- Ability to hear and see
decreases
- Time perception is distorted
- Speed of moving objects is
distorted
○ That’s why bawal mag drive
while you are intoxicated with
alcohol
Ethanol Metabolism
ALCOHOL
Absorbed in the GI tract
Absorbed by inhalation of vapors
90%-98%
MAJOR ROUTES OF ETHANOL DISPOSAL
- converted by the liver
(elevation of liver enzymes)
0.5%-1.5%
MAJOR ROUTES OF ETHANOL DISPOSAL
- Perspiration and respiration
with the lung
Remainder
MAJOR ROUTES OF ETHANOL DISPOSAL
- excreted by the kidney
- Serum because it reflects the
concentration of ethanol in the
brain
- When we collect test, do not
use alcohol as disinfectant
MAJOR ROUTES OF ETHANOL DISPOSAL
Sample
Methanol
ALCOHOL
Major components of paints, varnishes, and paint
removers
- Ingestion leads to formation of formaldehyde and
formic acid
○ Common sa street kids nga nay ginasimhot
Isopropanol
ALCOHOL
- Twice the CNS depressant as ethanol but not as
toxic as methanol
- ________is converted to acetone by the ADH
Rubbing alcohol
ALCOHOL
Isopropanol Common form
CARBON MONOXIDE
- is a colorless, odorless, tasteless gas.
- Very very toxic substance
- Product of incomplete combustion of carbon containing substances
- Binds to HEME PROTEINS
CARBON MONOXIDE
Mechanism of
action
Hemoglobin
CARBON MONOXIDE
Mechanism of
action
- it will compete with bindings
sites with oxygen
Cytochrome
CARBON MONOXIDE
Mechanism of
action
inhibit cellular respiration and
electron transport
20% CO
CARBON MONOXIDE Toxic Level
Brain and Heart
CARBON MONOXIDE Susceptible organs
100% oxygen
CARBON MONOXIDE Antidote
- Whole Blood using EDTA
CARBON MONOXIDE Sample used
Cherry red color of the face
CARBON MONOXIDE Indication of
acute toxicity
oxygen bind with the
hemoglobin in the RBCs
CARBON MONOXIDE
○ In the hemoglobin, ang mu attach is the ________________.
carbon monoxide will bind with the
hemoglobin very tightly
CARBON MONOXIDE
○ In the case of carbon monoxide__________________________, so instead na oxygen ang mu bind, it’s the
carbon monoxide.
hypoxia
CARBON MONOXIDE
What will happen is that it will result to_________ since low naman
ang oxygen na madeliver to the cells and tissues
inhibit cellular respiration
also inhibit
electron transport
CARBON MONOXIDE
Kung sa cytochrome, the same mechanism with the myoglobin. It
will _______________ at the same time, it will ___________ si carbon monoxide the same with cyanide.

CYANIDE
- Super toxic substance
● it is fast acting meaning kung ma expose ka, it could result to
death in an hour
- Component of insecticides, rodenticide
- It’s a common suicidal agent
solid, a gas, or in solution.
CYANIDE
can exist either as_____________
Burning of plastic
CYANIDE
● ______________ can also result to cyanide gas.
binding to the iron-containing
substances in the body. (e.g, hemoglobin, cytochrome)
CYANIDE
It expresses its toxicity by_____________________
cellular or tissue hypoxia
CYANIDE
if mu bind siya with the iron in the hemoglobin and
cytochrome, it will lead to ____________. Kay ma
replace napud again si oxygen, and mainhibit again ang
cellular and electron transport
formation of ATP
CYANIDE
It will also prevent__________ for energy
- inhalation, ingestion, and transdermal absorption
CYANIDE
Exposure
- Odor of bitter almonds in the breath, altered mental
status
CYANIDE
Indication
of Toxicity
2 – Strep strategy
CYANIDE
Antidotes
- Oxidants (amyl nitrite and
sodium nitrite)
- Sodium thiosulfate
Hydroxocobalamin
CYANIDE
Antidotes
most common because it’s
just one step
○ Siya ang mubind kay cyanide
para dili maka bind sa
cytochrome
cytochrome a3
CYANIDE
When cyanide reaches the cells, it binds with ___________,a
subunit of the cytochrome oxidase complex.
blocking the oxygen and preventing the cell from being able
to use it.
CYANIDE ○ Effect:
Hydroxocobalamin
CYANIDE
○ __________ binds with cyanide to form nonotoxic
cyanocobalamin, which is then excreted in the urine.
large quantities
METALS
- All metals can be toxic if ingested in ____________
Mercury
METALS
- Elemental, mercurous, mercuric and alkyl
mercury
- _______ has this unique ability of being able to
amalgam (able to mix or merge with other
substances
- Considered to be potent enzyme inhibitor
- Inhibit catecholamines
inhalation, ingestion,
cutaneous, tattoo, dental
amalgams (inhale or absorb, it
could pass thru the
Blood-brain barrier)
Mercury
Exposures
- Binds to sulfhydryl group of
protein
Mercury
Mechanism of
action:
Blood or urine (24hr
Mercury Sample
- Gastric lavage
○ Ipasuka or e cleanse ang
stomach
Mercury Antidote
Reinsch Test
Mercury Method of Testing
Blood-brain barrier
Central Nervous System
Mercury
Remember that if mainhale or maabsorb nimo
siya through the skin, it could pass thru the
_________which is delikado, pwede siya
moaccumulate in the _________
loss of glomerular integrity
Mercury
○ Also, the presence of mercury in the blood may
result to_________________ which is sa
kidney nimo
Elemental
mercury
Mercury Type
- pink disease
Alkyl mercury
Mercury Type
Minamata disease
Arsenic
METALS
- Found in pesticides, weed killer and some paints
- Component of ant poison, rodenticides, pain and
metal alloys
- Inorganic (Soil & Sediments in the Water), organic
and arsine gas
- Binds to the sulfhydryl group
of Hgb (able to cross the
placental, maka adto sa fetus)
ARSENIC MECHANISM OF ACTION
INGESTATION, INHALATION
ARSENIC EXPOSURE
- Blood and urine
○ Both are for short term
assessment, acute toxicity
○ For long term: hair and nails
(exhibit lines)
ARSENIC SPECIMEN
- British Anti-Lewisite (BAL)
○ it will trigger extreme vomiting
ARSENIC ANTIDOTE
odor of garlic, metallic taste in
the mouth
ARSENIC INDICATION OF TOXICITY
- Reinsch Test,
- Atomic Absorption
Spectroscopy (AAS)
ARSENIC METHOD OF TESTING
Lead
METALS
- nafamous due to news about toys from a certain
country contains a _______ in their paint
- Paint/ Soil/Gasoline
- Attach to RBC
- Aminolevulinic Acid (ALA)
LEAD POTENT ENYME INHIBITOR
● the first compound in
the Porphyrin
Synthesis (which is ang
mu lead sa Heme
- Respiratory (Inhalation)
- GI (Ingestion)
LEAD EXPOSURE
Child/Adult
LEAD SYMPTOMS
Venous Blood;EDTA
LEAD SPECIMEN
- Basophilic Stippling, ALA and
Porphyrin in the urine
LEAD INDICATON OF TOXICITY
Cadmium
METAL
- Manufacture of batteries, metal plating, plastic
● Pwede nimo maingest si ____________ if imong
food is acidic and you placed it in a metal
nga balonan that contains _____________
- Higher in females due to differences in iron stores
● There is increased _________ for those who
are Iron Deficient
- Inhalation (damage the lungs)
- ingested (damage the tubules
of the kidneys)
CADMIUM EXPOSURE TYPE
● damage to the Type 1
Epithelial Cells in your
lungs and madecrease
ang bacterial
resistance to
BINDS TO RBC
CADMIUM MECHANISM OF ACTION
URINE AND WHOLE BLOOD
CADMIUM SPECIMEN
PROTEINURIA
CADMIUM INDICATION
Amine derivatives with Benzine Ring
- Most all Drugs of Abuse are __________________,
and most of this DOA, ilang effect is in the neurotransmitter system;
ila awat-awaton si Dopamine
Amphetamines
DRUGS OF ABUSE
- Used therapeutically for Narcolepsy and ADHD;
Gina abuse lang and some kay modified form
which is called DESIGNER DRUG
- E.g., Ecstacy (MDMA), (MDEA)
- Effect: cause the release of dopamine from the
brain leading to a pleasant feeling
- Upon testing of ___________ like sa Drug
Screening, if nag drink ug antihistamine si
patient it could lead to false-positive reaction.
Anabolic
Steroids
DRUGS OF ABUSE
- Chemically related to testosterone because
these are performance enhancing drugs.
- Bawal ni siya because it will improve the athletic
performance of an athlete by increasing the
muscle mass
Cannabinoids
(Marijuana)
DRUGS OF ABUSE
- Naturally occurring _________ which is found
in the plant; Cannabis sativa;
- Hallucinogen – cause hallucinations
- Detected in the urine within 3-5 days; if chronic
user, 4 weeks